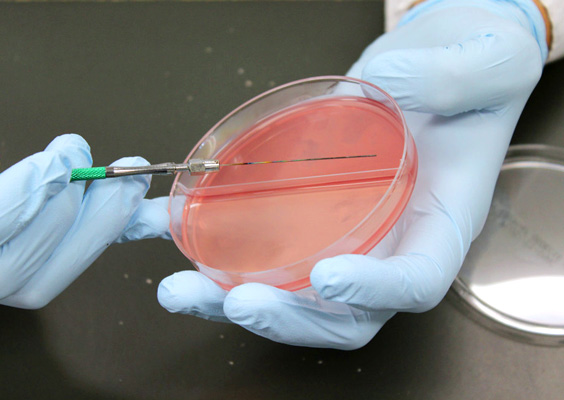

Q Tbn 3aand9gcse4swfaybfszei7yvbducy4zfgprf5gzifn17miiv0gjm8hrjx Usqp Cau

09年5月のブログ記事一覧 気分はnot So Bad

大人の検便 検便は ウンチの表面をやさしくなでる が正解 Open Doctors オープンドクターズ
検便 量 少ないとどうなる のギャラリー

よくあるご質問 森山環境科学研究所

ワクチン接種 W ハイブリッドコーギーmonji Low

速報 検便のやり方で気をつけるべき7つのこと 田辺ひゃくいちの冒険
運 K S裏blog Turuの一声

プレッシャー Welcome To Our House

正しい便のとりかた 真 あぁドドメ色の珍生

大腸がんを早期発見するために 大腸ct検査をご存知ですか ミッドタウンクリニック名駅 Jpタワー名古屋の人間ドック 健康診断

ノロウィルス検便検査 細菌検査 栄養成分検査 検便などの食品検査 食品微生物センター

公開公報 2ページ目 検便用に関する技術公報一覧 Astamuse

腸内細菌検査 赤痢 サルモネラ 腸チフス パラチフス O 157 東京都23区 多摩地区 八王子市 日野市 多摩市 立川市 府中市 調布市 福生市 羽村市 町田市 東久留米 東村山市 昭島市 あきる野市 国立市 青梅市 日の出町 瑞穂町その他

保存版 検便のやり方10選 下痢も便秘も生理でもお任せあれ きになるきにする
検便 18年6月 診療ブログ

健康診断 新 ジュラの世迷い言

腸内細菌検査 赤痢 サルモネラ 腸チフス パラチフス O 157 東京都23区 多摩地区 八王子市 日野市 多摩市 立川市 府中市 調布市 福生市 羽村市 町田市 東久留米 東村山市 昭島市 あきる野市 国立市 青梅市 日の出町 瑞穂町その他

尿の取り方で困ったことはありませんか 動物の医学 東浦和の動物病院なら 口コミで好評のドルフィンアニマルホスピタル
検便 18年6月 診療ブログ
Q Tbn 3aand9gcq 9yfjrcgyhuxr6 Mk9wknvadi Etbnqaq153wl70ffofqhkbu Usqp Cau

最近の検便事情16
Www City Chiyoda Lg Jp Documents 1618 Torikata Pdf

Amazon 郵送型 大腸がん検査キット2回法 自宅で検便 定性検査 便潜血検査 郵送検査キットセンター ガンリスク検査

検便検査 株式会社関西環境センター
検便を出し忘れて3日間バックの中に放置してしまいました こ Yahoo 知恵袋

公開公報 2ページ目 検便用に関する技術公報一覧 Astamuse

便検査でうまくとれない 少ない時や溶ける場合はどうしたら良いの ちょっとした工夫で心豊かな生活を

検便における正しい採便方法 飲食品取扱者 検便 お役立ち情報 株式会社 東邦微生物病研究所

Images Of 検便 Japaneseclass Jp

速報 検便のやり方で気をつけるべき7つのこと 田辺ひゃくいちの冒険

検便 量が多過ぎると検査出来ないのはなぜ 硬い便でも大丈夫 役立ちログ
検便 引き篭もりな日々

検便における正しい採便方法 飲食品取扱者 検便 お役立ち情報 株式会社 東邦微生物病研究所

検便検査 陽性者 の対応について O157 サルモネラ ノロウイルス 環境未来株式会社

検便の量 多すぎですってな 写真共有サイト フォト蔵

検便検査 検便検査のことなら食環研

便検査でうまくとれない 少ない時や溶ける場合はどうしたら良いの ちょっとした工夫で心豊かな生活を

便検査でうまくとれない 少ない時や溶ける場合はどうしたら良いの ちょっとした工夫で心豊かな生活を

お家に帰りたい 健全検便

初めての検便風景をふりかえった 魁 腹筋塾

採便について 細菌検査 検査 公益財団法人 愛媛県総合保健協会

検便は何日前のもので大丈夫 出ない時の対処方法は Hapila ハピラ

オプション検査詳細 社会医療法人博愛会 開西病院

大腸がん検診を受ける時の注意 けんこうリンク 公益財団法人 茨城県総合健診協会

検体検査 地方独立行政法人神戸市民病院機構 神戸市立医療センター西市民病院

公開公報 2ページ目 検便用に関する技術公報一覧 Astamuse
洋式トイレの採便で失敗しない 手軽な検便のやり方

大腸がん 増加傾向 こんな症状に注意を 日テレnews24

犬の検便 猫の検便で分かる病気とは モフマガ By ペットホームウェブ

検便用の名前ラベル 検体袋の使用方法 飲食品取扱者 検便 お役立ち情報 株式会社 東邦微生物病研究所
Q Tbn 3aand9gcsb Yeplfd8m9xxc405rbhl5juco9ao6gn2krteso5etalaxcgk Usqp Cau

検便における正しい採便方法 飲食品取扱者 検便 お役立ち情報 株式会社 東邦微生物病研究所

便潜血検査について 痛みの少ない大腸内視鏡検査は川越駅前胃腸 肛門クリニック 埼玉県
Q Tbn 3aand9gct8ey5vdf Tivxd3uor5gbv G37dflug F7hbjpnuy7sjcxnkwg Usqp Cau

検便 今夜もゆかいなぱーてぃーだ

検便

おしりから血 痔よりも怖い大腸がんのサイン 女性のためのおしりのはなし 野澤真木子 毎日新聞 医療プレミア

保菌 検便 検査について ハートメディカル 株式会社
Lkm博士のブログ 協同乳業 ウン小話アーカイブ

追加検査 検便 指定難病75 クッシング病 の記録

ピロリ菌検査キット通販 効果 その他病気 検査キット オオサカ堂

大人の検便 検便は ウンチの表面をやさしくなでる が正解 Open Doctors オープンドクターズ

検体採取のしかた 便 痰 尿 検査相談室 各種ご相談 ご利用案内 豊島病院

検便における正しい採便方法 飲食品取扱者 検便 お役立ち情報 株式会社 東邦微生物病研究所
検便の袋なんですが この提出日っていうのも書いたほうがいいんで Yahoo 知恵袋

検便 Happyに行こう 楽天ブログ

大腸がんを早期発見するために 大腸ct検査をご存知ですか ミッドタウンクリニック名駅 Jpタワー名古屋の人間ドック 健康診断

医療法人 結和会 松山西病院

検査の現場から発信 環境 検査お役立ち情報 環境未来株式会社

検便で 採った便が少なすぎるとダメですか 液体が入った容器と Yahoo 知恵袋

採取方法 Hedgehog Style
親切なプリント By ぱやん エッセイ投稿サービスshortnote ショートノート
マルマの検査 分析サービスの特徴 検査 分析 サービス紹介 総合衛生管理の株式会社マルマ 害虫 シロアリ防除駆除 検査 殺菌 清掃 モノクロラミン消毒 静岡 浜松

鶴岡地区食品衛生協会 会員の健康管理 検便などの実施

腸内細菌検査 検便 細菌担当 奈良県公式ホームページ

まあええか人生 病院のトイレで悲を叫ぶ ずっこけ検便噺 健康診断パートii 産経west

よくあるご質問 森山環境科学研究所
新しい職場にて 検便を提出するように と 容器をもらいました が 使い方 Yahoo 知恵袋

便検査おすすめの採取方法は トイレの水が多い場合は 水没したら ちょっとした工夫で心豊かな生活を

検便について ガールズちゃんねる Girls Channel

検便 ノロウイルス リアルタイムpcr法 森山環境科学研究所

検便って水没したら使えない 検便初心者でも失敗しない方法 楽しく役に立つ情報をお届けします のんびっき

食物繊維不足はこれでチェック 大塚製薬

どうやるの 検便のやり方 採取方法まとめ Icoro

洋式トイレの採便で失敗しない 手軽な検便のやり方

Amazon 郵送型 大腸がん検査キット2回法 自宅で検便 定性検査 便潜血検査 郵送検査キットセンター ガンリスク検査

健康診断の 検便 で分かること 注意すること 医者が教える病気のブログ

日本癌学会 第22回日本癌学会市民公開講座 講演4 がん予防法とがん検診 大腸がんを中心に

徳谷 柿次郎 明日は最新の人間ドック受ける プレッシャーに追いやられた前夜検便 最近のはこんな感じなんだな トレールペーパーのありがたさ そして見本ウンコのリアルさ いい

検便検査 陽性者 の対応について O157 サルモネラ ノロウイルス 環境未来株式会社
Http Ousar Lib Okayama U Ac Jp Files Public 1 87 409 Pdf

検便 Wikipedia

週末ブログ 第45弾 The 検便編 戦略室ブログ

検便のための洋式便器の構造

検便 アラフォーオヤジのなにわ日記

検便 失敗 人間ドックで失敗しない わかりやすい体験記 Part 検便は大事編

Amazon 郵送型 大腸がん検査キット2回法 自宅で検便 定性検査 便潜血検査 郵送検査キットセンター ガンリスク検査

どうやるの 検便のやり方 採取方法まとめ Icoro

検便って水没したら使えない 検便初心者でも失敗しない方法 楽しく役に立つ情報をお届けします のんびっき

検便における正しい採便方法 飲食品取扱者 検便 お役立ち情報 株式会社 東邦微生物病研究所

なぜ毎月 定期 の検便検査が必要ですか 意義や義務の有無 O157 サルモネラ 赤痢など食中毒菌を解説します 検査を身近に もっと便利に 環境未来web

Plenty Of Horn Ted Curson

検便における正しい採便方法 飲食品取扱者 検便 お役立ち情報 株式会社 東邦微生物病研究所
Http Www Kyoto Kyoritsu Org Dl Pr Binnobin 02 Pdf



